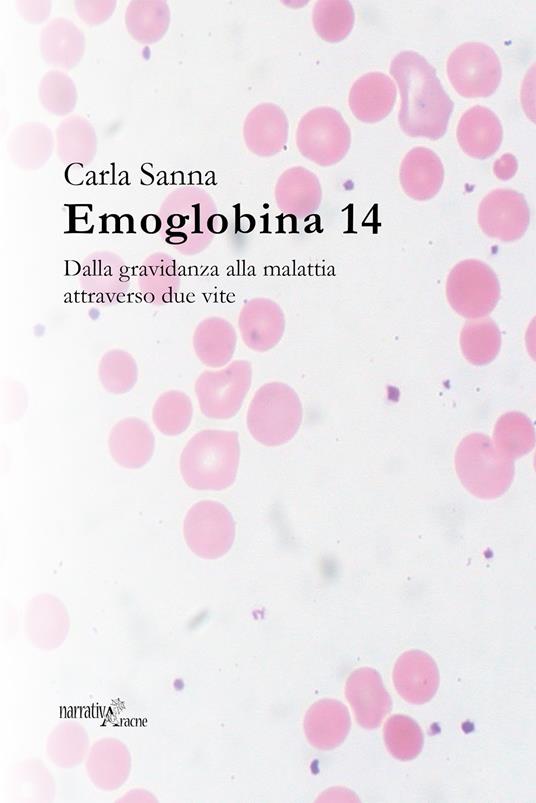
Emoglobina 14. Dalla gravidanza alla malattia attraverso due vite - Carla Sanna - copertina

Emoglobina 14. Dalla gravidanza alla malattia attraverso due vite
Carla, una giovane donna sui trent'anni, è alla sua prima gravidanza. Euforia e gioia pura fino al giorno del parto. Arrivata in clinica per partorire naturalmente, subirà gravi lesioni a seguito di un parto cesareo sbrigativo, eseguito per salvare il bambino. La fretta le sarà fatale. Sarà dimessa dopo tre giorni con un'emorragia in corso e rischierà la vita innumerevoli volte, affrontando svariate operazioni. Dopo venti giorni di terapia intensiva, tra la vita e la morte, sarà trasferita in un centro di ematologia per affrontare un rarissimo difetto della coagulazione sopraggiunto a seguito delle emorragie interne. Per due mesi resterà lontana da suo figlio appena nato, affidato nel frattempo alle cure del padre e dei nonni.
Venditore:

-
Autore:
-
Editore:
-
Collana:
-
Anno edizione:2017
Le schede prodotto sono aggiornate in conformità al Regolamento UE 988/2023. Laddove ci fossero taluni dati non disponibili per ragioni indipendenti da Feltrinelli, vi informiamo che stiamo compiendo ogni ragionevole sforzo per inserirli. Vi invitiamo a controllare periodicamente il sito www.lafeltrinelli.it per eventuali novità e aggiornamenti.
Per le vendite di prodotti da terze parti, ciascun venditore si assume la piena e diretta responsabilità per la commercializzazione del prodotto e per la sua conformità al Regolamento UE 988/2023, nonché alle normative nazionali ed europee vigenti.
Per informazioni sulla sicurezza dei prodotti, contattare productsafety@feltrinelli.it